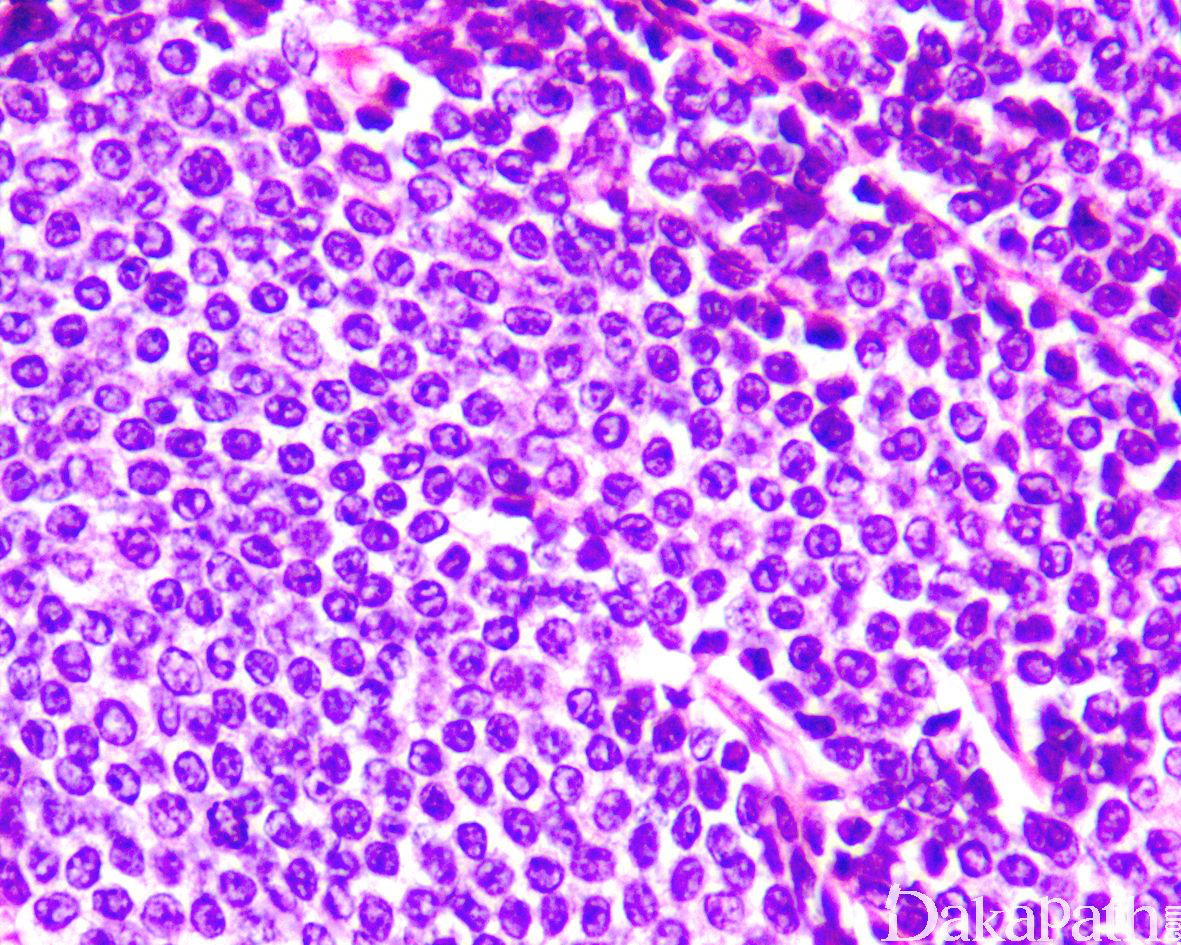

乳腺实性小叶癌
Breast Solid Lobular Carcinoma
同义词(或曾用名): 乳腺浸润性小叶癌变异型
概述:
属于浸润性小叶癌的变异型,占浸润性小叶癌比例约 5-10%。
发病部位: 乳腺
诊断要点:
细胞索大于 2 层细胞宽度,由胶原纤维分割,细胞黏附差,似淋巴瘤;
细胞与经典型小叶癌一样,形态一致,小到中等大,呈轻度非典型性(I 级细胞核),细胞核多偏于一侧,染色稍深,无明显核仁,核分裂像少见,多数细胞有胞质内黏液空泡,偶见印戒细胞样形态,但是与经典型小叶癌相比,细胞更具多形性,核分裂更多;
常合并经典型浸润性小叶癌区域,多位于病变边缘;
肿瘤细胞弥漫浸润周围组织形成大片实性结构,间质稀少,可见坏死,类似淋巴瘤或转移性黑色素瘤;
小叶原位癌成分不如经典型小叶癌常见。

免疫组织化学染色:
P120 胞浆阳性;E-Cadherin 阴性或弱阳性。
鉴别诊断:
淋巴瘤:
乳腺淋巴瘤可以为原发于乳腺间质、乳腺内淋巴结的淋巴瘤,也可以是全身系统性淋巴瘤的一部分;
肿瘤常常形成结节或小叶状,但不累及正常乳腺导管和小叶;
一般不伴有小叶原位癌;
上皮和淋巴组织免疫组化标记很容易将二者区别开。
转移性黑色素瘤:
乳腺最常见的转移性恶性肿瘤,诊断时原发部位可以是隐匿性的;
通常为界限清楚的肿瘤,细胞之间缺乏粘附性,瘤细胞核仁较明显;
缺乏小叶原位癌成分;
黑色素瘤免疫组化标记,如 HMB45, MelanA, S-100 等阳性,细胞角蛋白阴性有助鉴别。
预后:
较经典型乳腺小叶癌预后差,12 年生存率约 64%。
参考文献:
Fechner RE. Histologic variants of infiltrating lobular carcinoma of the breast. Hum Pathol. 1975;6(3):373‐378. du Toit RS, Locker AP, Ellis IO, Elston CW, Nicholson RI, Blamey RW. Invasive lobular carcinomas of the breast--the prognosis of histopathological subtypes. Br J Cancer. 1989;60(4):605‐609. Tadros AB, Wen HY, Morrow M. Breast Cancers of Special Histologic Subtypes Are Biologically Diverse. Ann Surg Oncol. 2018;25(11):3158‐3164.
